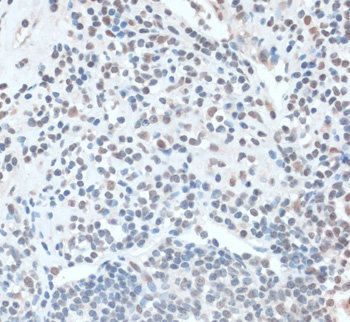

Filters
Clonality
Type
Reactivity
Gene Name
Isotype
Host
Application
Clone
7106 results for " Mouse" - showing 1100-1150
Semaphorin 3, ELISA Kit (Cat# AAA16070)
Leukotriene C4, ELISA Kit (Cat# AAA16582)
apolipoprotein C-III, ELISA Kit (Cat# AAA18374)
CD3, Monoclonal Antibody (Cat# AAA26822)
DEPDC6, Polyclonal Antibody (Cat# AAA22212)
Growth Differentiation Factor 3, ELISA Kit (Cat# AAA16075)
GDNF family receptor alpha like, ELISA Kit (Cat# AAA18123)
PaRathyroid Hormone Related Protein, ELISA Kit (Cat# AAA16086)
Hyaluronan and proteoglycan link protein 1 (HAPLN1), ELISA Kit (Cat# AAA27105)
Matrix metalloproteinase 2, ELISA Kit (Cat# AAA16099)
Beta-Defensin 14, ELISA Kit (Cat# AAA17138)
Kallikrein 1-related peptidase b3 (Klk3), ELISA Kit (Cat# AAA15085)
Vanin 1 (VNN1), Polyclonal Antibody (Cat# AAA20071)
Elastin, Monoclonal Antibody (Cat# AAA20819)
Ovalbumin, Monoclonal Antibody (Cat# AAA20826)
collagen, type I, alpha 2, Polyclonal Antibody (Cat# AAA15910)
ASGR1, Polyclonal Antibody (Cat# AAA27911)
Predicted: Mouse, Rat